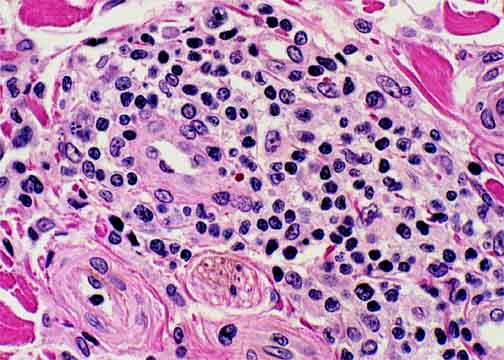

Go to:

TOC
|
Peripheral T-Cell Lymphomas: Example 2A
This is a case of PTCL minimally but exclusively involving the skin. It is not mycosis fungoides, in part because there is no epidermal involvement. The lymphoma progressed to a more aggressive histology in Example 2B. Despite the relatively tame appearance of the cells in this specimen, the neoplasm ultimately killed the patient.

There are bluish clumps of malignant T-cells in the superficial and deeper dermis, mostly around vessels and adnexa. Unlike mycosis fungoides, the epidermis is not involved, so that the strip of papillary dermis immediately beneath the epidermis is uninvolved. This is called the "Grenz zone", from the German word for border. This is an example of a peripheral T-cell lymphoma involving only the skin at this stage of its career. Although the depth of the lesion and the occasional atypical cell (see below) are clues to its malignancy, one might hesitate to make a diagnosis of lymphoma were it not for molecular diagostic studies. These showed clonal rearrangements of the J-beta 1 and 2 genes. |
A higher power view of a malignant, perivascular cluster. Although the atypical cells are not obvious rogues and are not present in throngs, clearly some of these lymphoid cells are not merely small, mature-appearing lymphocytes. |

Table of Contents 
|



